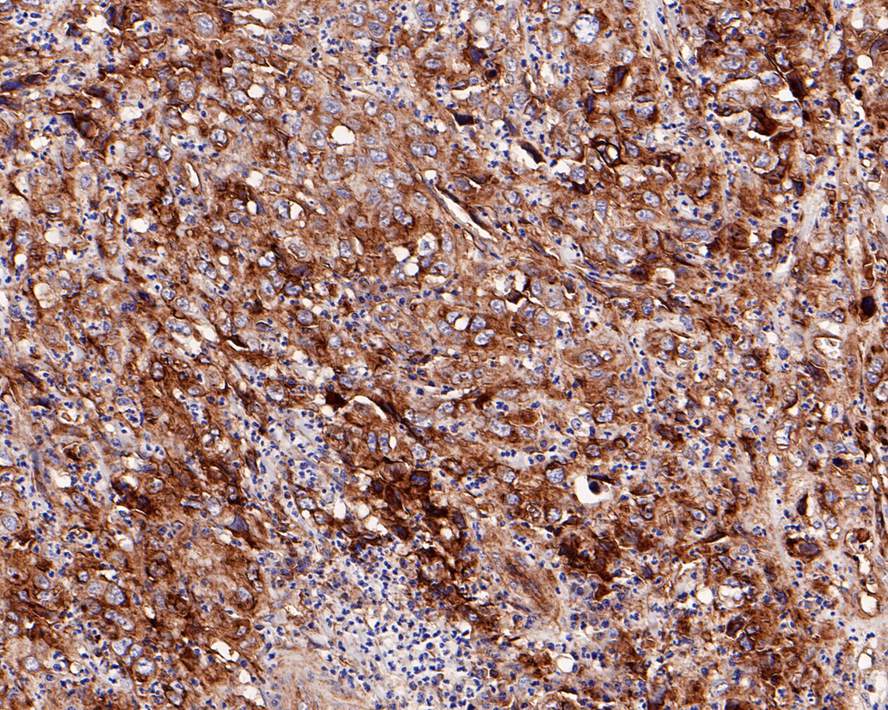

Integrin beta 1 Recombinant Rabbit Monoclonal Antibody [SA40-08] - BSA and Azide free

Catalog# HA750008
Integrin beta 1 Recombinant Rabbit Monoclonal Antibody [SA40-08] - BSA and Azide free
Application
-
WB
-
IHC-P
Reactivity
-
Human
-
Mouse
-
Rat
With BSA and Azide
-
ET1601-17
含抗保成分
Predicted reactivity
 预测的种属支持售后
预测的种属支持售后
-
Zebrafish
Conjugation
-
unconjugated

浙公网安备 33019202000643号
浙公网安备 33019202000643号